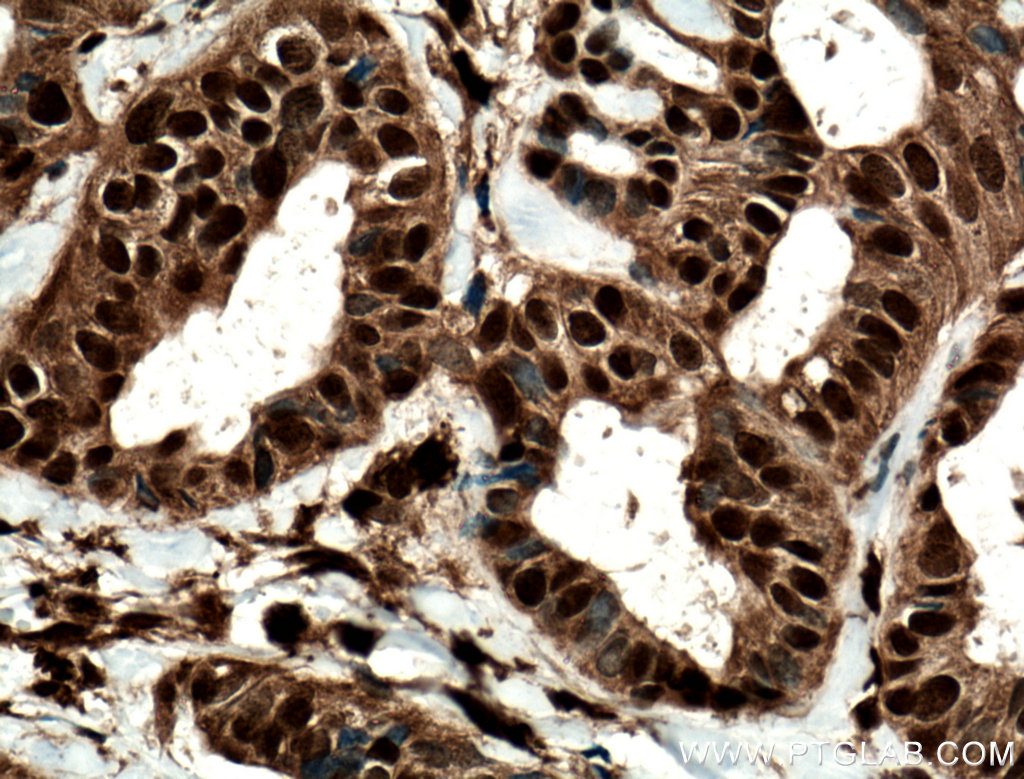

验证数据展示
经过测试的应用
| Positive WB detected in | K-562 cells, 3T3-L1 cells, Daudi cells, DU 145 cells, SGC-7901 cells |
| Positive IP detected in | K-562 cells, 3T3-L1 cells |
| Positive IHC detected in | human cervical cancer tissue, human breast cancer tissue Note: suggested antigen retrieval with TE buffer pH 9.0; (*) Alternatively, antigen retrieval may be performed with citrate buffer pH 6.0 |
| Positive FC (Intra) detected in | MCF-7 cells |
推荐稀释比
| 应用 | 推荐稀释比 |
|---|---|
| Western Blot (WB) | WB : 1:1000-1:8000 |
| Immunoprecipitation (IP) | IP : 0.5-4.0 ug for 1.0-3.0 mg of total protein lysate |
| Immunohistochemistry (IHC) | IHC : 1:50-1:500 |
| Flow Cytometry (FC) (INTRA) | FC (INTRA) : 0.25 ug per 10^6 cells in a 100 µl suspension |
| It is recommended that this reagent should be titrated in each testing system to obtain optimal results. | |
| Sample-dependent, Check data in validation data gallery. | |
产品信息
13179-1-AP targets STAT5A/B in WB, IHC, IF, FC (Intra), IP, ELISA applications and shows reactivity with human, mouse, rat samples.
| 经测试应用 | WB, IHC, FC (Intra), IP, ELISA Application Description |
| 文献引用应用 | WB, IHC, IF |
| 经测试反应性 | human, mouse, rat |
| 文献引用反应性 | human, mouse, rat, bovine, cow |
| 免疫原 |
CatNo: Ag3846 Product name: Recombinant human STAT5A protein Source: e coli.-derived, PGEX-4T Tag: GST Domain: 445-794 aa of BC027036 Sequence: ESQFSVGSNELVFQVKTLSLPVVVIVHGSQDHNATATVLWDNAFAEPGRVPFAVPDKVLWPQLCEALNMKFKAEVQSNRGLTKENLVFLAQKLFNNSSSHLEDYSGLSVSWSQFNRENLPGWNYTFWQWFDGVMEVLKKHHKPHWNDGAILGFVNKQQAHDLLINKPDGTFLLRFSDSEIGGITIAWKFDSPERNLWNLKPFTTRDFSIRSLADRLGDLSYLIYVFPDRPKDEVFSKYYTPVLAKAVDGYVKPQIKQVVPEFVNASADAGGSSATYMDQAPSPAVCPQAPYNMYPQNPDHVLDQDGEFDLDETMDVARHVEELLRRPMDSLDSRLSPPAGLFTSARGSLS 种属同源性预测 |
| 宿主/亚型 | Rabbit / IgG |
| 抗体类别 | Polyclonal |
| 产品类型 | Antibody |
| 全称 | signal transducer and activator of transcription 5A |
| 别名 | STAT5A, MGF, STAT5 |
| 计算分子量 | 794 aa, 92 kDa |
| 观测分子量 | 90-95 kDa |
| GenBank蛋白编号 | BC027036 |
| 基因名称 | STAT5A |
| Gene ID (NCBI) | 6776 |
| RRID | AB_2196760 |
| 偶联类型 | Unconjugated |
| 形式 | Liquid |
| 纯化方式 | Antigen affinity purification |
| UNIPROT ID | P42229 |
| 储存缓冲液 | PBS with 0.02% sodium azide and 50% glycerol, pH 7.3. |
| 储存条件 | Store at -20°C. Stable for one year after shipment. Aliquoting is unnecessary for -20oC storage. |
背景介绍
STAT5A, also named as STAT5, belongs to the transcription factor STAT family. In response to cytokines and growth factors, STAT family members are phosphorylated by the receptor associated kinases, and then form homo- or heterodimers that translocate to the cell nucleus where they act as transcription activators. STAT5A is activated by, and mediates the responses of many cell ligands, such as IL2, IL3, IL7 GM-CSF, erythropoietin, thrombopoietin, and different growth hormones. Activation of STAT5A in myeloma and lymphoma associated with a TEL/JAK2 gene fusion is independent of cell stimulus and has been shown to be essential for the tumorigenesis. The mouse counterpart of human STAT5A is found to induce the expression of BCL2L1/BCL-X(L), which suggests the antiapoptotic function of STAT5A in cells. This antibody is a rabbit polyclonal antibody raised against 445-794 aa of human STAT5A, the homology between this segment and the corresponding segment of human STAT5B is 92%. It shows that this antibody can cross-react with STAT5B.
实验方案
| Product Specific Protocols | |
|---|---|
| FC protocol for STAT5A/B antibody 13179-1-AP | Download protocol |
| IHC protocol for STAT5A/B antibody 13179-1-AP | Download protocol |
| IP protocol for STAT5A/B antibody 13179-1-AP | Download protocol |
| WB protocol for STAT5A/B antibody 13179-1-AP | Download protocol |
| Standard Protocols | |
|---|---|
| Click here to view our Standard Protocols |
发表文章
| Species | Application | Title |
|---|---|---|
Carbohydr Polym Structural characterizations and antiaging activities of hydrolyzed low-molecular-weight polysaccharides from Polygoni Multiflori Radix Praeparata | ||
Front Immunol Exhausted signature and regulatory network of NK cells in myasthenia gravis | ||
Front Immunol Elevated levels of exogenous prolactin promote inflammation at the maternal-fetal interface via the JAK2/STAT5B signaling axis | ||
Chemosphere MEHP promotes liver fibrosis by down-regulating STAT5A in BRL-3A hepatocytes.
| ||
Endocrinology A Novel Mechanism of hPRL-G129R, A Prolactin Antagonist, Inhibits Human Breast Cancer Cell Proliferation and Migration | ||
Front Oncol In-depth analysis of the expression and functions of signal transducers and activators of transcription in human ovarian cancer |